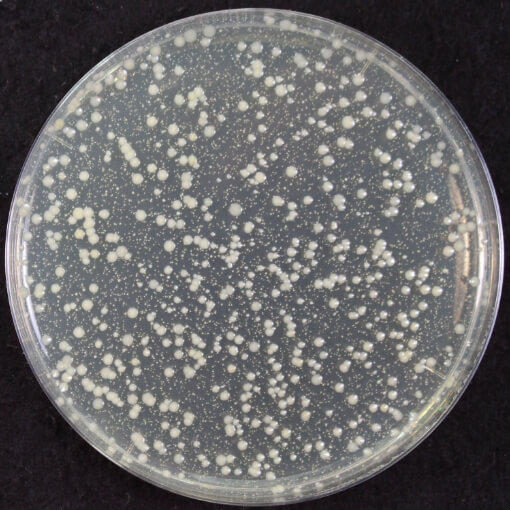
UV照射前イメージ
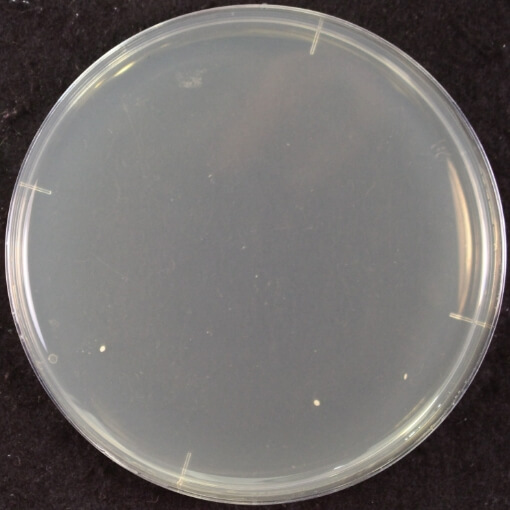
UV照射15分後イメージ

TECHNOLOGY
その小さなボディからは
想像もできないほどにパワフル。
最大16Jの高出力で、
太く濃い毛までしっかりアプローチします。
定期的なフェイスケアにも
照射力をおさえたフェイス専用モードを搭載。
身体だけでなく、顔まわりの使用が可能です。
太くて硬い毛にも、男性のひげにも効果を実感いただけます。
照射力をおさえたフェイス専用モードを搭載。
-

未処理
-

8週間の使用
モード:FACE 出力レベル:4
照射頻度:3日に1度
照射回数:560回数(1回につき約30回) -

16週間の使用
モード:FACE 出力レベル:4
照射頻度:3日に1度
照射回数:1120回数(1回につき約30回)
照射面が瞬時に10℃まで低下。
快適さを支える、ダブル冷却性能
照射面には、高い熱伝導率を有するサファイアクリスタルを採用。
小型の冷蔵庫にも使われるペルチェ素子を組み合わせることで、
高い冷却効果を発揮、快適なケアを実現します。
-

-

*冷却ありなしの比較画像(肌に照射面を当て放した時の温度分布)
片腕だけなら約3分*で完了。
最速1.3秒間隔*の
オート照射機能で超時短ケア!
超時短ケアを可能にしたオート照射機能を搭載。
手軽に習慣化でき、効果の実感につながります。
*BODYモードのLevel1、
またはCAREモード使用時の社内測定値

衛生面に革新。
クリーニング専用の
UVスタンド
除菌※
使い終わった後は付属のUVスタンドへ。
照射面を除菌し、清潔な状態にリセットします。いつでも清潔を保てるから、
パートナーや家族との共用もおすすめです。
-
照射なしの場合
-
15分照射の場合
※本体の照射面に付着させた菌のイメージ画像
※ 試験依頼先:(一財)北里環境科学センター ⚫試験方法:本体の照射面に付着させた菌(1種類)の生菌数測定 ⚫除菌の方法:本体をUVスタンドに設置し、UVを照射 ⚫対象部分:本体の照射面 ⚫試験結果:15分後、99%以上の除菌効果 ⚫報告書番号:北生発2025_0165号





